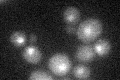
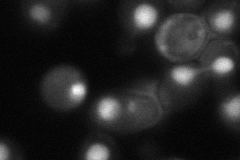

View description
Member of the REF (RNA and export factor binding proteins) family; when overexpressed, can substitute for the function of Yra1p in export of poly(A)+ mRNA from the nucleus
Localization:
Intensity:
Fold change:
Significance:
-
C’ GFP library in SD
nucleus21.64 -
N' NOP1pr-GFP in SD

nucleus186.245 -
N' TEF2pr-mCherry in SD

nucleus343.11 -
N' NATIVEpr-GFP in SD

nucleus23.7938 -
N' TEF2pr-VC and Cyto-VN in SD
nucleus66.7307 -
C’ GFP library in SD+DTT

nucleus22.481.03No -
C’ GFP library in SD+H2O2

nucleus18.030.83No -
C’ GFP library in Starvation Media

nucleus31.051.43Yes -
C’ GFP library on the background of Pup2-DaMP

nucleus -
C’ GFP library on the background of CCT mutant

nucleus19.97290.922849No
